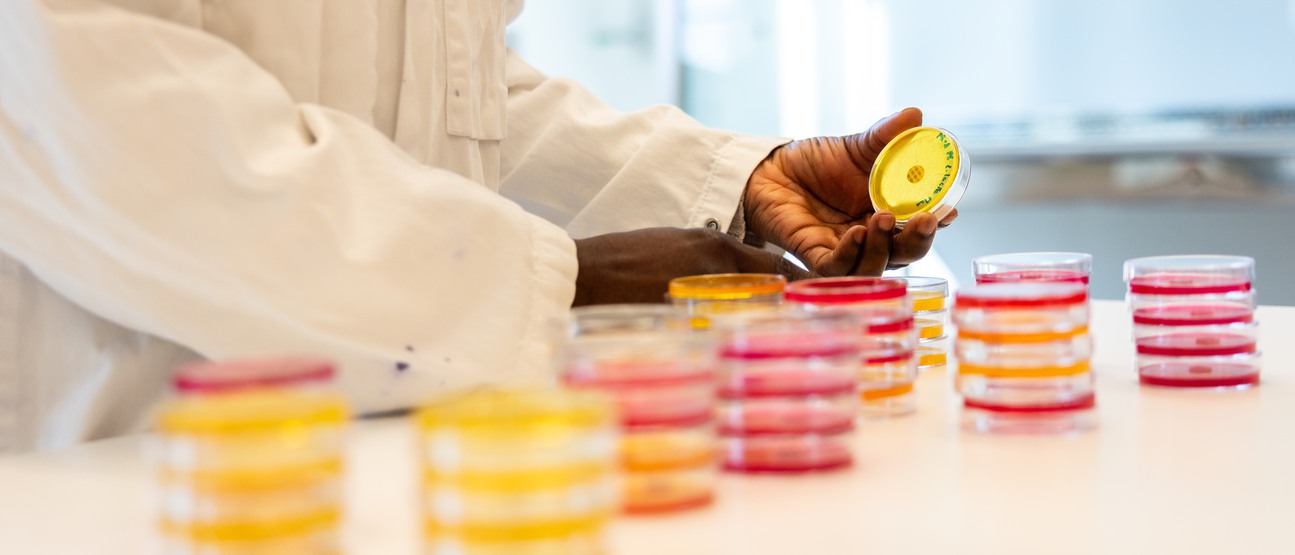

Katarina Brantingson Skogfält
Institutionen för hälsovetenskaper

Vi forskar på varför barn utvecklar typ 1 diabetes. Vi vet att kroppens immunförsvar av misstag börjar angripa de celler som producerar insulin, men det är fortfarande oklart vad som triggar igång den processen.
I vår forskning studerar vi hur olika proteininteraktioner fungerar hos barn som nyligen fått diagnosen typ 1 diabetes samt hos dem med långvarig sjukdom, och om immunsystemet reagerar olika på dessa interaktioner.
Vår förhoppning är att förstå de bakomliggande orsakerna till sjukdomen, kunna förebygga insjuknande – och på sikt öka chanserna att hitta ett botemedel.
Projektet genomförs i samarbete med Skaraborgs sjukhus, Göteborgs universitet och Michigan State University, och delfinansieras av Skaraborgsinstitutet.

